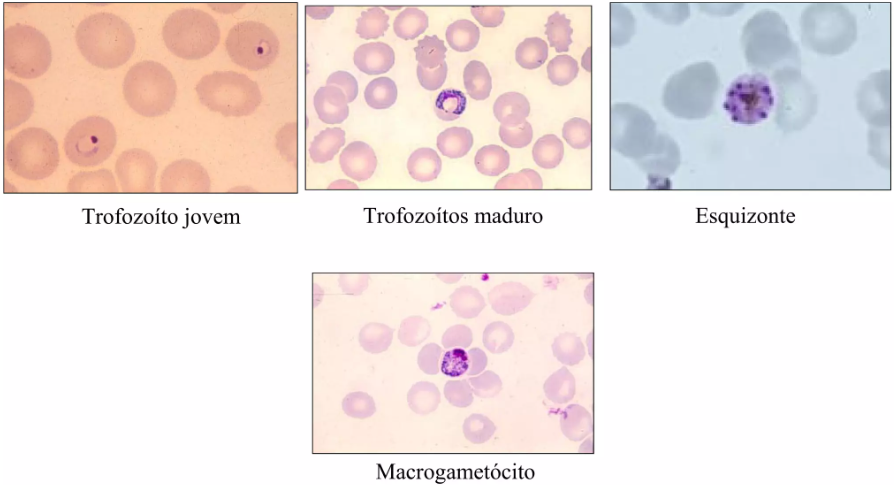

Qual o agente etiológico da malária?
Plasmodium Falciparum
Plasmodium Vivax
Plasmodium Malariae
Plasmodium Ovale
Quais são as formas evolutivas do plasmodium em seu ciclo?
Segundomaterial:
-Merozoita
-Trofozoita jovem
-Trofozoita maduro
-Esquizonte
-Rosácea
-Gametócito
Qual a forma do plasmódium que emerge dos hepatócitos?
Merozoita

Durante o ciclo sanguíneo do plasmódium, na forma vista na lâmina, ele está dentro de que célula?
Dos eritrócitos
Qual a primeira forma assumida pelo plasmódium após ser merozoita?
Trofozoita jovem

A divisão nuclear realizada pelo plasmódium se chama…
Esquizogonia, em que se divide o núcleo e depois o citoplasma do patógeno
Constitui dentro do eritrócito vários indivíduos isolados chamados merozoitos
Ou seja, um trofozoita é feito de vários merozoitos
Qual a característica da forma equizonte?
Tem-se múltiplos núcleos vistos num único citoplasma

Quando o plasmódium entra na forma de rosácea?
Logo após ser equizonte, em que a progressão das divisões celulares levam a individualização dos parasitas no sangue, virando merozoitos infectivos de eritrócitos
O conjunto de merozoitos infectivos = rosácea
Qual o nome dado à forma latente do Plasmodium vivax e onde ele fica latente?
São chamados de hipnozoítas
Ficam latentes nos hepatócitos
Podem causadr episódios tardios de malária
Como ocorre a transmissão da malária?
Pela picada do mosquito Anopheles infectados com o plasmódium spp
Os mosquitos injetam a forma esporozoíta infectiva do plasmódium, e este vai ao fígado para se reproduzir nos hepatócitos, originando os merozoitas

No período pós-infecção, no sangue do indivíduo se manifesta que forma do plasmódium?
A forma de gametócito.
Essa forma pode ser inoculada no Anopheles quando este pica o indivíduo.
Os gametócitos se fecundam no inseto e dão origem à forma de esporozoito, que pode então ir infectar outros indivíduos
Quando os merozoitas infectam os eritrócitos da corrente sanguíena, eles se tornam…
Se tornam trofozoitas jovens
Estes amadurecem e entram posteriormente na forma de equizontes
Os merozoitas que eclodem a partir dos esquizontes na corrente sanguínea são os mesmos que saem dos hepatócitos na infecção inicial?
Sim
Este é o ciclo exponencial de proliferação do parasita
Quais são os caminhos do merozoita após eclodirem a partir do equizonte?
Eles podem:
Se manter na forma merozoita e ir infectar novas hemácias
Se diferenciar em sua forma gametócita fem/masc, que podem vir a ser sugados por Anopheles, realizar ciclo sexuado no vetor e ir infectar outra pessoa
O que é o ciclo pré-eritrocítico?
É o processo dentro do fígado em que os esporozoitas inoculados vão se multiplicar nos hepatócitos, viram merozoitos por esquizogonia e vão para o sangue infectar hemácias
O que é o ciclo eritrocítico ?
Quando os merozoitas saem dos hepatócitos ao sangue e vão se multiplicar/infectar as hemácias
O ciclo de transformações do plasmodium dentro do eritrócito deste a introdução do merozoito até saída da rosácea dura quanto tempo?
48h para P. falciparum
72h para P. malariae
A eclosão das hemácias são as definidoras da recorrência da febre como sintoma da malária
Febre terçã, quartã,…
O que determina a patogenia da malária?
Definição dos seus sintomas e alterações morfofuncionais no indivíduo?
Destruição das hemácias infectadas = anemia + febrec/ intervalos regulares
Toxicidade por liberação de hemozoína
Citocinas
Lesões capilares por depósito de antígeno-anticorpo
Quando e como é possível diagnóstico da malária?
Diante dos sintomas da fase eritrocítica (fase pré-eritrocítica é indetectável):
-Febre em intervalos regulares
-Anemia
Diagnóstico laboratorial via esfregaços
Como é feito o tratamento da malária?
Cloroquina principalmente



